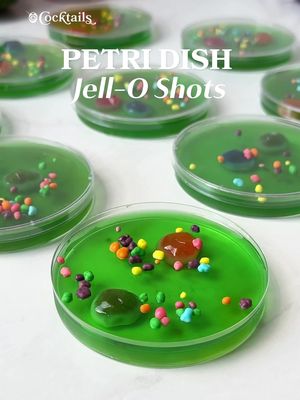

NewClaim a free social report
followers
2.65M
impressions
46.1M
likes
1.45M
comments
6.34K
posts
777
engagement
3.17%
emv
$1.29M
Average per post
59.3K
Key Metrics
Impressions
monthly
Distributions
Content

2.71M
117K
172
7mo ago
cocktails
I’m dreaming of a white Christmas…margarita. 🎄 -1.5 oz. tequila -1 oz. coconut milk -1 oz. coconut water -1/2 oz. triple sec or orange liqueur -1/2 oz. lime juice -sugared rosemary & cranberries #christmas #whitechristmas #margarita #christmascocktails #holidays

2.19M
145K
258
7mo ago
cocktails
The perfect sip to celebrate National Gingerbread Day 🤎 Pro tip: snag the Gingerbread Cookie Mug Hangers at Trader Joe's to take your cocktail to the next level. Grab the coupe glasses at the link in our bio. -1 oz. vanilla vodka -2 oz. Baileys -1/2 oz. gingerbread syrup -2 oz. half & half -whipped cream, gingerbread crumbs, caramel sauce & mini gingerbread man for garnish @cocktails may earn commission through links on our social. #gingerbread #martini #dessertcocktails #christmas #holidaycocktails

1.53M
26.9K
238
2mo ago
cocktails
Which ice cream should we pair with red wine next? Drop your flavor ideas in the comments. 🍷 #redwine #icecream #strawberry #wine #pairings

1.41M
52.9K
45
3mo ago
cocktails
Summer in a glass. 🥭 -1 cup frozen mango -3 oz. Aperol -2 oz. orange juice -2 oz. prosecco -handful of ice -sliced orange and mango for garnish #frozencocktails #aperolspritz #aperol #mango #Summer

1.39M
4.35K
36
3mo ago
cocktails
#ad Turning up the heat with @Sprite Zero Sugar. 🌶️

1.31M
62.0K
67
3mo ago
cocktails
Happy National Margarita Day! 🍋🟩✨ Ingredients: - 2 oz. peach purée - 1.5 oz. tequila - .5 oz. Cointreau - .5 oz. lime juice - a few dashes of hot honey - rim glass with hot honey and Tajín - garnish with a peach slice #nationalmargaritaday #margarita #hothoney #peach #cocktails

1.28M
33.8K
56
3mo ago
cocktails
Snowy weeks call for a pitcher of limoncello sangria 🍋❄️ -1 cup strawberries, sliced -1 cup sliced lemon -1/2 cup limoncello -1 bottle Sauvignon Blanc -club soda, for topping off #sangria #limoncello #batchcocktails #wine #whitewine

1.19M
39.5K
645
10mo ago
cocktails
Dessert served the right way.🍷 #redwine #wine #drink #dessert #icecream #combo #icecreamandwine

1.16M
33.0K
16
6mo ago
cocktails
Add a bit of sparkle to your holiday season with this winter wonderland cosmopolitan ✨❄️ -2 oz. vodka -1 oz. triple sec -1.5 oz. white cranberry juice -1/2 oz. lime juice -coarse sugar & lime for rim -sugared cranberries #cosmo #christmas #christmascocktails #vodka #holidaycocktails

1.07M
832
5
4mo ago
cocktails
#ad Send this Spicy Zerojito to your spiciest friend. @Sprite

1.06M
37.3K
72
6mo ago
cocktails
Keeping it festive all season long with these sugar cookie shots 🎄 Grab the shot glasses at the link in our bio. -3 oz. Baileys -2 oz. milk -3 oz. vodka -2 oz. amaretto -frosting & holiday sprinkles @cocktails may earn commission through links on our social. #sugarcookieshots #christmas #christmascocktails #shots #cocktails
1.04M
112K
295
8mo ago
cocktails
Petri dish Jell-O shots are eerie, yet endearing✨Link for the petri dishes is in our bio. @cocktails may earn commission through links in our socials. -3 oz. lime Jell-O mix -1 cup boiling water -1/2 cup cold water -1/2 cup. vodka -Gushers & Nerds #petridishjelloshots #petridish #jelloshots #halloween #vodka

890K
27.5K
93
6mo ago
cocktails
Two flavors are better than one ✨❤️. Recipe inspo: @Champagne Ang Strawberry Layer: -3 oz. strawberry Jell-O mix -1 cup boiling water -1/2 cup vodka -1/2 cup cold water White Layer: -7 oz. sweetened condensed milk -1 cup boiling water -1 packet gelatin Garnish: -whipped cream -crushed candy canes #tiltedjelloshots #christmas #peppermint #candycane #jelloshots

870K
56.7K
472
9mo ago
cocktails
Layers of fall magic in a cup 🍂✨ Pumpkin + Fireball = the ultimate cozy dessert. Pumpkin Cake: -1 box white cake mix -4 eggs -1/2 cup oil -1 (15 oz.) can pumpkin puree -1/4 cup sugar -1/4 cup water -1 tsp. each cinnamon & pumpkin pie spice Whipped Cream: -6 oz. cream cheese, softened -3/4 cup powdered sugar -1.5 cups heavy cream -1/8 cup Fireball -1 tsp. cinnamon -caramel sauce -Fireball shooters #pumpkinfireballtrifles #pumpkin #fireball #trifles #falldesserts

808K
14.1K
90
11mo ago
cocktails
Splash into summer with these Adult Capri Suns ☀️ Only three ingredients needed. -bag of frozen fruit -vodka -lemonade #adultcaprisun #caprisun #vodka #lemonade #fruit #Summer

798K
8.74K
48
5mo ago
cocktails
Ring in the new year with these prosecco-soaked cotton candy grapes. 🍾🎆 Ingredients: -cotton candy grapes -prosecco -sugar #newyears #newyearseve #prosecco #grapes #boozy

718K
32.2K
51
1mo ago
cocktails

658K
16.4K
50
2mo ago
cocktails
Almost too pretty to eat (almost!)✨ Ingredients (makes about 15 slices): - 6 lemons sliced in half and carved - 2/3 cup hot water - 2 packs unflavored gelatin (.25 oz. each) - 2/3 cup fresh squeezed lemon juice - 2/3 cup Empress gin - 1/3 cup lavender simple syrup Steps: 1. Slice lemons in half then use a spoon to remove flesh. 2. Place inside of lemons in a bowl and muddle to remove the juice. 3. Once muddled, strain into a measuring cup to remove any pulp or seeds. Should have about 2/3 cup lemon juice 4. Place carved lemon cups in a baking dish, make sure they are stable and standing 5. Bring water to a boil then turn heat to low 6. Sprinkle unflavored gelatin on top of water and allow to bloom for 3 minutes 7. Whisk gelatin until completely dissolved 8. Remove from heat then whisk in fresh lemon juice, Empress gin, and lavender simple syrup 9. Once combined, pour into lemon cups then place in the fridge for 3-4 hours 10. Once shots are firm, remove from the fridge and place on a cutting board. Slice lemon shots in half, knife touching the Jell-O shot first. 11. Once your shots are perfectly sliced, garnish with a sprinkle of granulated sugar. 12. Serve on a plate with mint and enjoy! #lemon #lavender #lemonade #jelloshots #spring

634K
30.5K
64
11mo ago
cocktails
Peach szn is upon us. 🍑 #peach #hothoney #margarita #tequila #cocktail #Summer

556K
12.0K
142
9mo ago
cocktails
Serve your wine in festive style 🎃 This is your sign to add a wine bag to your pumpkins this season. #pumpkin #wine #winedispenser #halloween #fall
@cocktails (@cocktails) Tiktok Stats & Analytics
@cocktails (@cocktails) has 2.65M Tiktok followers with a 3.17% engagement rate over the past 12 months. Across 777 videos, @cocktails received 1.45M total likes and 46.1M views, averaging 1.87K likes per video. This page tracks @cocktails's performance metrics, top content, and engagement trends — updated daily.
@cocktails (@cocktails) Tiktok Analytics FAQ
How many TikTok followers does @cocktails have?+
@cocktails (@cocktails) has 2.65M TikTok followers as of June 2026.
What is @cocktails's TikTok engagement rate?+
@cocktails's TikTok engagement rate is 3.17% over the last 12 months, based on 777 videos.
How many likes does @cocktails get on TikTok?+
@cocktails received 1.45M total likes across 777 videos in the last 12 months, averaging 1.87K likes per video.
How many TikTok views does @cocktails get?+
@cocktails's TikTok content generated 46.1M total views over the last 12 months.